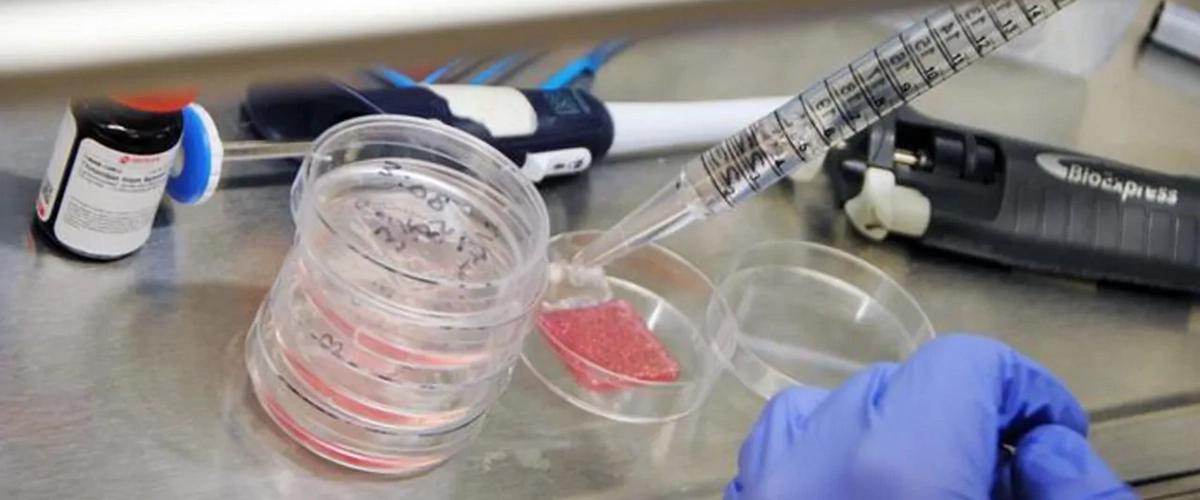
TODO:

Это исследование включало биопечать всех шести основных типов первичных клеток человека, присутствующих в коже, в сочетании со специализированным гидрогелем в качестве биочернил. Была создана многослойная кожа полной толщины, содержащая все три слоя, присутствующие в нормальной ткани человека: эпидермис, дерму и гиподерму.
В результате трансплантации биопечатного материала на животных сформировались кровеносные сосуды, характерные узоры кожи и нормальная структура тканей. Дополнительные аспекты исследования показали, что этот подход способствует улучшению заживления ран, снижению сокращения кожи и увеличению производства коллагена, что уменьшает образование рубцов.
Команда доказала, что полностью функциональная регенерация кожи возможна. Биоинженерные кожные трансплантаты имеют трехслойную структуру, обеспечивающую покрытие раны на всю толщину.
Технология могла бы помочь жертвам ожогов, раненым и людям с кожными заболеваниями.